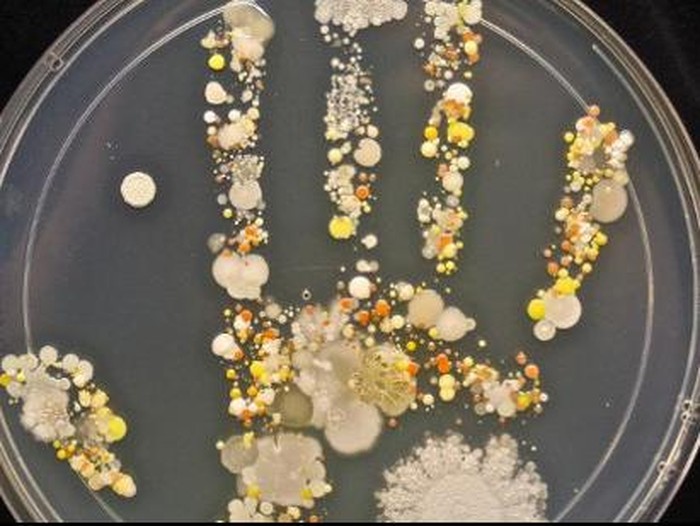
Di Tangan Ibu Ini, Cap Tangan Penuh Bakteri Bisa Jadi Gambar yang Indah

Saat bermain di luar rumah, anak Tasha gemar melompat di genangan lumpur dan menggenggam serangga. Bahkan mengonsumsi kudapan yang sudah jatuh. Pada satu titik orang tua memang harus lebih waspada terhadap bakteri dan kuman yang bisa berbahaya untuk kesehatan anak. Namun, Tasha justru melihat adanya bakteri indah berwarna-warni, fungi dan jamur lain yang terdapat pada handprint anak 8 tahun itu.
Tasha adalah seorang mikrobiologis di Cabrillo College yang memposting foto dari handprint ke aplikasi MicrobeWorld app. Warna yang ditimbulkan oleh bakteri hampir mirip dengan warna bunga pada tahun 70-an. Tentu saja pertumbuhan bakteri bisa terakumulasi setelah beberapa hari jika seseorang tidak rajin mencuci tangan hingga bersih.
ADVERTISEMENT
SCROLL TO CONTINUE WITH CONTENT
Ia mencatat beberapa bakteri yang terlihat di cawan petri adalah Staphylococcus dan Micrococcus yang memang biasanya ditemukan di tangan manusia. Dia juga mengatakan gumpalan besar yang melebar di sudut kanan bawah kemungkinan adalah sebuah komunitas batang Bacillus yang umum ditemukan di tanah. Dan pada warna cenderung cerah adalah fungi dan beberapa jenis lain dari jamur.
"Banyak kuman yang menempel pada tangan seusai menyentuh sesuatu dengan langsung maupun tidak langsung. Di antaranya termasuk Salmonella, E. coli dan Norovirus," ucap perwakilan dari Centers for Disease Control and Prevention (CDC), dikutip dari Medical Daily, Jumat (19/6/2015)
Begitu banyaknya kuman membuat manusia harus terbiasa mencuci tangan terutama bagi anak-anak yang suka bermain di luar. Mereka lebih rentan terkena infeksi karena sistem kekebalan tubuhnya yang masih lemah. Bayangkan saat tangan mereka penuh bakteri lalu menyentuh wajah, mata, hidung bahkan organ vital. Tentu saja hal itu bisa menjadi pintu masuknya bakteri ke dalam tubuh anak. CDC menyarankan agar mencuci tangan dengan sabun dan air bersih setiap selesai beraktivitas.
Jangan lupa untuk menggosok sela-sela jari dan dibawah kuku minimal selama 20 detik. Kemudian bilas dengan bersih dengan air mengalir. Jangan lupa keringkan tangan dengan handuk atau mesin pengering guna menghindari kontaminasi ulang.
Baca juga : Ibu Pengganti Terunik, Kecanduan Hamil Hingga 13 Kali Lahirkan Anak Orang
(rdn/up)